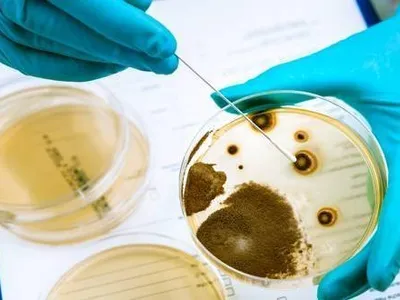

Spania se confruntă cu cea mai agresivă epidemie de gripă din ultimii 15 ani, iar numărul cazurilor crește rapid. Marile orașe, inclusiv Barcelona, au intrat în alertă, iar autoritățile au impus din nou purtarea măștii în anumite zone pentru a limita răspândirea virusului.